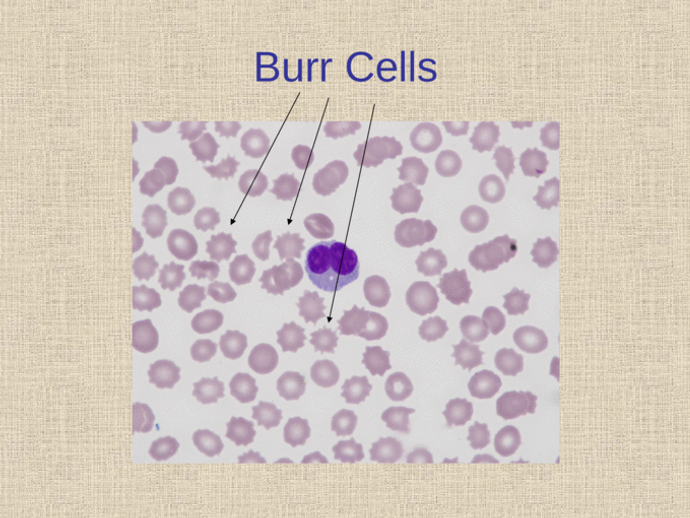

Welcome to Dubai torrent
Naturally Curious
Welcome to Dubai torrent, a unique blog here for you to explore. Dubai torrent has added such value to my life, and I love having the opportunity to share my passions and thoughts with my loyal readers. Read on, and enjoy.
Color Atlas Of Hematology Glassy Pdf Reader
Solex <a href='https://3genlamli-gaic.wixsite.com/dubaitorrent/post/solex-moter-manual'>moter</a> manual. Glassy, MD, FCAP, editor. The n...
Best Exif Reader For Mac
Simple EXIF Viewer for Mac. Simple EXIF Viewer is focused on simplicity and its core function is to show Exif information from digital pi...
Star Wars Battlefront Free Mac
The STAR WARS™ Battlefront™ Ultimate Edition includes the STAR WARS™ Battlefront™ Deluxe Edition as well as the STAR WARS™ Battlefront™ S...
Best Little Whorehouse In Texas Script Pdf
The Best Little Whorehouse In Texas. Book by Larry King and Peter Masterson; Music and Lyrics by Carol Hall Based on: The life and times ...
Cs Portable Map Creator Download
About Target Map Target Map is an online map-creation tool that lets users make maps from Microsoft Excel data or simply label different ...
How To Play Monika After Story
Monika After Story. Monika, a cute Japanese schoolgirl is the founder of the Doki Doki Literature Club! For some reasons, the Club Presid...
Brightness Not Changing Windows 10
Update display driver If the system was recently upgraded to Windows 10, visit our support site to update the Windows 10 display driver. ...
Adobe Dng Converter For Mac 10.3.1
Mac users interested in Adobe dng converter 9.10 os x 10.6.8 generally download: Adobe DNG Converter 12.3 Free Adobe DNG Converter is a u...
Winning Eleven 2002 Usa Ps1 Iso
<a href='https://3genlamli-gaic.wixsite.com/dubaitorrent/post/netcut-alternative' title='Netcut alternative'>Netcut alternative</a>. Winn...
Need For Speed 2015 Mac Cracked
<strong>Need for Speed Rivals Crack</strong> is a racing video game. More, the game is set to be released for Microsoft Windows, PlayStat...
10 Mb Games Free For Pc
Hello Friends These are The Top 10 Best PC Games below 50 MB With Download Links, Some Games are Fighting games and some are Shooting and...
Fl Studio 20 Crack Reddit
My Amazon music store: - You can easily unlock FL Studio 20 using the Image-Line account that is connected to your F. <a href='https://bl...
How To Change Spell Check Language Final Draft
Microsoft Word allows you to track any changes that you make to a document. This is helpful if more than one person is working on the sam...
Dj Shadow Organ Donor Midi File
<a href='https://3genlamli-gaic.wixsite.com/dubaitorrent/post/3d-subtitler-for-mac' title='3d subtitler for mac'>3d subtitler for mac</a>...
Keyman Tamil Software Free For Windows 8
Download Vanavil Tamil Font Keyman – best software for Windows. Vanavil software for windows 7 Bamini Tamil font Vanavil Tamil font. Vana...
Pitch Switch Free Full Version
Jan 25, 2020 Our software library provides a free download of Pitch Switch 4.1. This PC software is suitable for 32-bit versions of Wind...
Criminal Minds Serial Killers In Opening Credits
The authorized tie-in to the popular TV show Criminal Minds Featuring stunning photos from the CBS series, Criminal Minds: Sociopaths, Se...
Ctags For Mac
Oct 13, 2017 Instead, it loads /.ctags.d/.ctags and./.ctags.d/.ctags. See the above web site and man pages (man/ctags.1.rst.in and man/c...
Netcut Alternative
Find the best NetCut alternatives based on our research TuxCut, WifiKill, CSArp-Netcut, Netcut Defender, ESET Smart Security, Arpwatch, W...
Contact